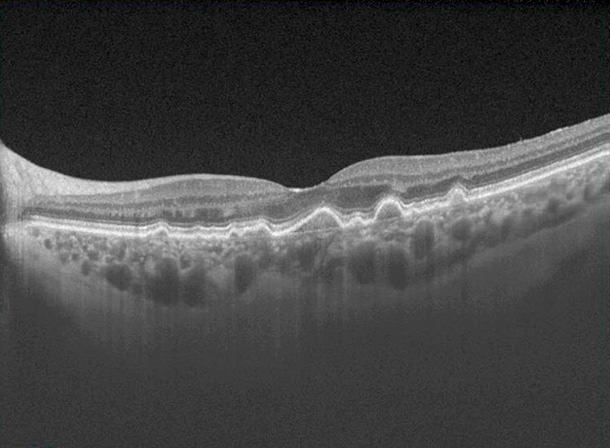
Tomografía de coherencia óptica macular que muestra las ondulaciones en las capas externas de la retina que corresponden a las drusas. DMAE seca - Tratamiento - Tomografía - VERTE Oftalmología Barcelona

La Degeneración Macular Asociada a la Edad seca ya tiene tratamiento
Se trata de uno de los acontecimientos más importantes en el campo de la retina de los últimos 10 años.
La Degeneración Macular Asociada a la Edad (DMAE) es actualmente la principal causa de ceguera irreversible en pacientes mayores de 50 años. Se trata de una enfermedad degenerativa que produce un envejecimiento selectivo de la mácula, por lo que su principal causa es la edad. Se prevé que el número de afectados alcance los 300 millones en 2040.
La Dra. Carme Macià, especialista de la Unidad de Retina y Vítreo de VERTE Oftalmología Barcelona, nos responde a unas cuantas preguntas acerca de esta enfermedad y nos explica por qué la aprobación de nuevos fármacos es un acontecimiento fundamental en el campo de la oftalmología.
¿Doctora, por qué es tan limitante la DMAE?
La DMAE afecta la parte central de la retina, donde se encuentra la visión central y se produce la fijación. Su conservación tiene un alto valor, ya que nos permite llevar a cabo actividades diarias y simples como leer, ver la televisión o conducir sin dificultad. Sus síntomas más comunes son experimentar visión central borrosa, o percibir una mancha en el campo visual.

¿Existen diversos tipos de DMAE?
Sí, de cada 10 pacientes con DMAE: 8 tienen DMAE seca y 2 tienen DMAE húmeda.
¿Es más perjudicial la DMAE seca o la húmeda?
Es más perjudicial la DMAE húmeda porque la pérdida de visión es más rápida. El tratamiento lo único que consigue es frenar la pérdida.
¿Qué es la DMAE atrófica?
También llamada DMAE seca. Es aquel tipo de DMAE sin líquido dentro de la retina. La pérdida es más lenta, pero al igual que la DMAE húmeda es también irreversible.
¿Por qué es tan preocupante la DMAE?
Porque es la primera causa de pérdida visual en pacientes con una edad superior a los 65 años.
¿Existe tratamiento para la DMAE seca o atrófica?
Hasta principios de este año 2023 no existía ningún tratamiento para este tipo de DMAE. De ahí la enorme importancia de la aprobación, aunque solo sea de momento en Estados Unidos, por primera vez a nivel mundial existe un tratamiento efectivo para esta enfermedad.
Se trata de uno de los acontecimientos más importantes en el campo de la retina de los últimos 10 años.
¿Cuántos fármacos existen para la DMAE seca o atrófica?
Existen 2 fármacos: el Syrfovre y el Izerbay.
Comparten muchas características:
- Han sido aprobados en Estados Unidos para la DMAE atrófica
- Los 2 se inyectan de forma intravítrea, mediante una inyección con anestesia tópica
- Tienen el mismo mecanismo de acción, mediante la regulación de la cascada del complemento (sistema que explicamos a continuación)
- Es importante iniciar el tratamiento antes de que la atrofia haya afectado la parte central de la mácula
- No es suficiente con una sola inyección, sino que el tratamiento tiene que aplicarse de forma periódica
- Se pueden inyectar de forma mensual o bimensual
¿El tratamiento consigue recuperar la visión perdida?
Desgraciadamente, los tratamientos para todos los tipos de DMAE son solo para frenar la pérdida visual. De ahí la enorme importancia del diagnóstico precoz, para poder empezar el tratamiento antes de que la pérdida sea incapacitante
¿Cómo actúan estos medicamentos?
Son fármacos biológicos y actúan a nivel molecular. Su función es ayudar a impedir que nuestro sistema de defensa o sistema inmunitario destruya las células del ojo. Lo hace inactivando el sistema de la cascada del complemento. El sistema del complemento son unas proteínas que nos ayudan para defendernos de las infecciones, pero que a veces se equivocan y en lugar de atacar microbios atacan a nuestras propias células del organismo. Estos fármacos en definitiva intentan evitar que esto ocurra.
¿Qué relación tiene el Complemento con la DMAE?
Se ha detectado que las drusas, que son unos depósitos que aparecen debajo de la retina en pacientes con formas iniciales de DMAE, están llenas de proteínas del sistema del complemento. También se ha detectado que mutaciones genéticas en este sistema del complemento se han asociado con un riesgo mayor de desarrollar DMAE. De ahí la convicción de que el sistema inmune participa, aunque solo sea en parte, en la génesis de la DMAE.
¿Puedo recibir este tratamiento en Europa?
Por el momento no, este tratamiento tan solo está disponible en Estados Unidos actualmente. Se aprobó por la FDA (U.S. Food and Drug Administration) los primeros meses de este año 2023. La Agencia Europea de Medicamentos está evaluando la solicitud de autorización de este nuevo medicamento y se espera que tome una decisión a lo largo de 2024. También está pendiente de ser aprobado en Canadá.
La DMAE es una enfermedad en constante estudio e investigación, representando un desafío importante en el campo de la oftalmología. Gracias a la incansable investigación oftalmológica y al avance de la ciencia, los pacientes con DMAE atrófica, junto con una detección precoz, pueden tener una esperanza significativa en su pronóstico. Este hecho se traduce en una mejora en la calidad de vida de estos pacientes, gracias a la posibilidad de frenar el avance de esta enfermedad y, en consecuencia, ralentizar la pérdida de visión.
A partir de los 50 años o en caso de experimentar algún cambio en la visión, desde VERTE Oftalmología Barcelona te recomendamos realizarte una exploración oftalmológica completa para descartar la aparición de alguna enfermedad oftalmológica. Pide cita con nuestros especialistas llamando al 934 155 637 o envíanos un WhatsApp AQUÍ.
